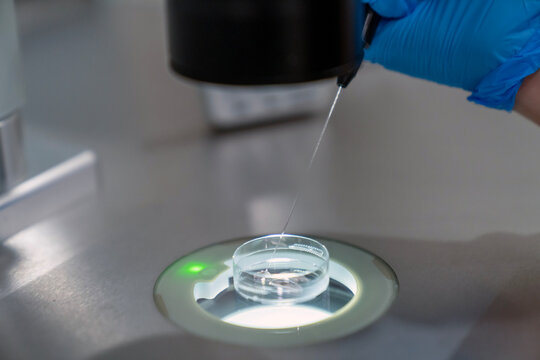
Professional embryologist using microscope for ICSI IVF procedure, microinjection of sperm into female egg cell in fertility clinic laboratory for assisted reproduction, human artificial insemination.

Kostnadsfri provperiod: Få 10 stockbilder plus AI-redigeringsverktyg
Kostnadsfri provperiod: Få 10 stockbilder plus AI-redigeringsverktyg
Nya filter har lagts till
Sortera efter
Välj region
Om du väljer region kan språket och kampanjinnehållet på Adobe Stock-webbplatsen ändras.
Nordamerika
Sydamerika
- Venezuela
- Algeria - English
- Armenia - English
- Azerbaijan - English
- Bahrain - English
- Belgium - English
- Belgique - Français
- België - Nederlands
- Česká republika
- Croatia - English
- Cyprus - English
- Danmark
- Georgia - English
- Deutschland
- Eesti
- Egypt - English
- España
- France
- Greece - English
- Iceland - English
- Ireland
Europa, Mellanöstern och Afrika
- Israel - English
- Italia
- Jordan - English
- Казахстан
- Kenya - English
- Kuwait - English
- Киргизия
- Latvija
- Lebanon - English
- Lietuva
- Luxembourg - Deutsch
- Luxembourg - English
- Luxembourg - Français
- Mauritius - English
- Moldova - English
- Hungary - English
- Malta - English
- Morocco - English
- Nederland
- Nigeria
- Norge
- Oman - English